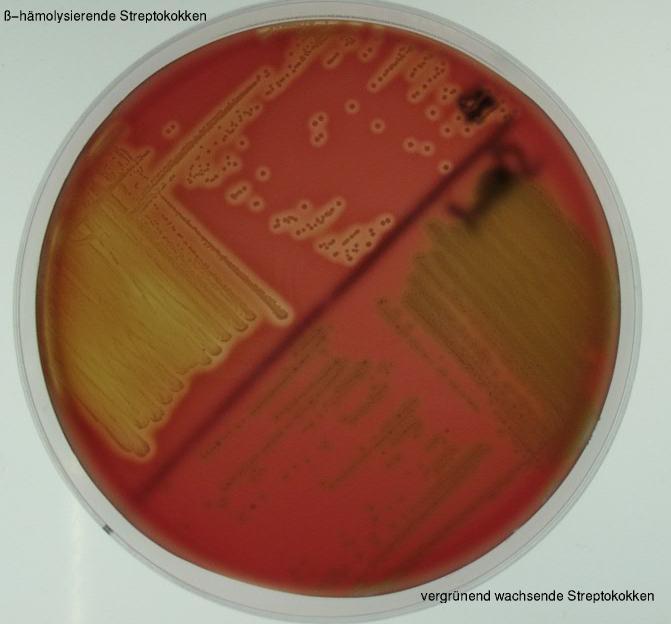

Streptokokken sind grampositive Kugelbakterien, die sich in Ketten lagern. Sie besitzen keine Katalase und sind deshalb bei Wachstum in Gegenwart von Sauerstoff auf Nährmedien angewiesen, die die Bildung von H2O2 (aus NADH2) verhindern. Dies ist z.B. der Blutagar.
Die Streptokokken zeigen eine typische Veränderung des Blutagars, die sich in der Nähe von Kolonien zeigt. Dabei können die Erythrozyten
vollständig aufgelöst werden (ß-Hämolyse) oder es kann die Farbe des Blutes verändert werden (sog. Vergrünung oder alpha-Hämolyse). Die Vergrünung kommt
durch eine Oxidation des Eisens im Häm zustande, was das Absorptionsspektrum des Hämoglobins ändert. Die Einteilung nach Hämolyseverhalten
ist günstig, weil ß-hämolysierende Streptokokken die pathogeneren Spezies darstellen, während vergrünend wachsende (alpha-hämolysierende) zur
Normalflora des Mund- und Rachenraumes gehören und normalerweise keine Infektionen verursachen (Ausnahmen s.u.).
Die nicht hämolysierende Streptokokken werden nach dieser Einteilung - etwas unglücklich -als gamma-hämolysierende Streptokokken bezeichnet.

Grampräparat von Streptokokken.
Die Bakterien liegen zu zweit oder in Ketten.
Man erkennt die vollständige Hämolyse auf der einen und die Vergrünung auf der anderen Seite. Die vollständige Hämolyse wird von extrazellulären Toxinen der Streptokokken hervorgerufen. Dies sind Proteine, die sich zu Oligomeren zusammen lagern und in Zellmembranen eindringen. Dies führt zur Ausbildung von Poren (Löchern) in den Zellmembranen, was die Lyse der Zellen zu Folge hat.